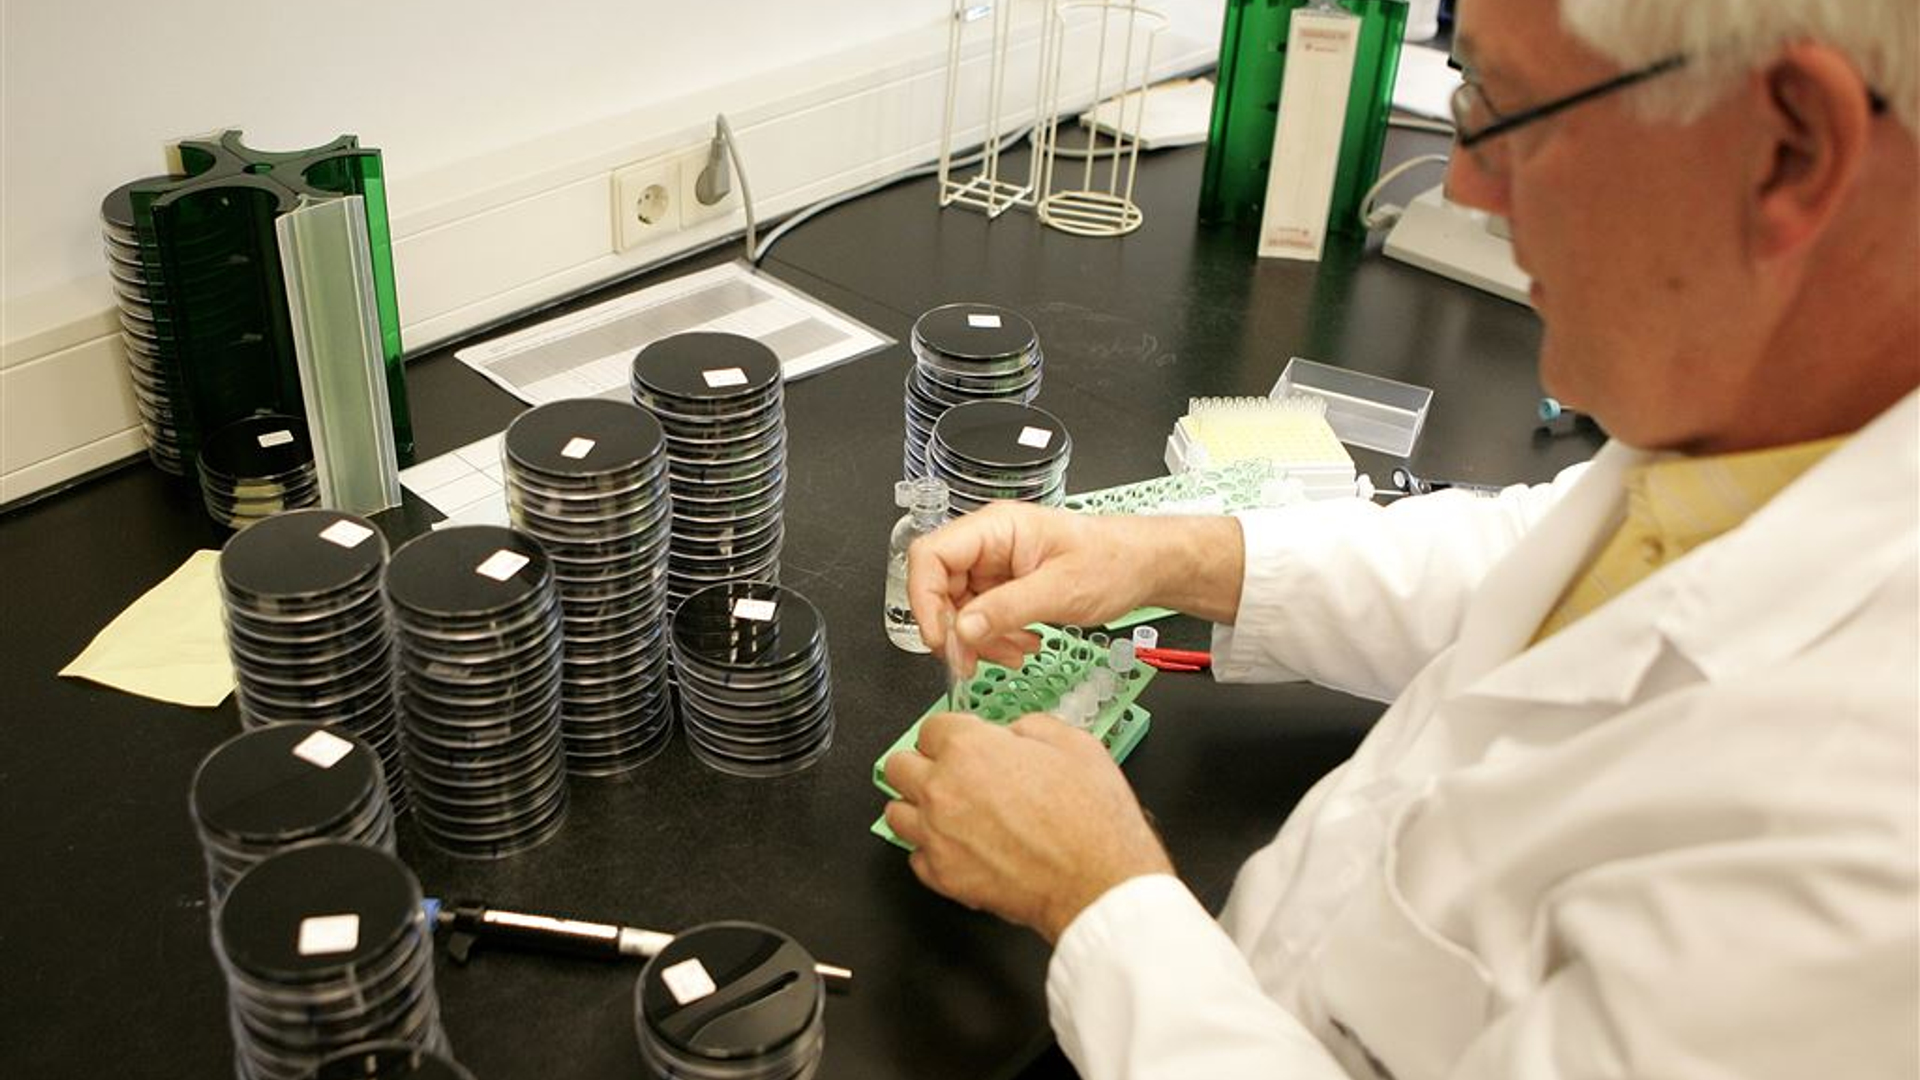
Legionella onderzoek

Zembla is het onderzoeksjournalistieke platform van BNNVARA.
Minister: meer onderzoek naar verspreiding van legionella
19-10-2018
•leestijd 2 minuten
•
Minister Cora van Nieuwenhuizen (Infrastructuur en Waterstaat) laat onderzoek doen naar de verspreiding van legionella door biologische waterzuiveringsinstallaties. Dat laat ze weten naar aanleiding van de gestegen verspreiding van de bacterie in Noord-Brabant.
"Directe verspreiding over grotere afstand vanuit zo’n biologische afvalwaterzuiveringsinstallatie was nog niet eerder aangetoond", schrijft ze aan de Tweede Kamer. Omdat dit onbekend was, staan hierover ook geen eisen in de regelgeving voor deze installaties.
"Directe verspreiding over grotere afstand vanuit zo’n biologische afvalwaterzuiveringsinstallatie was nog niet eerder aangetoond", schrijft ze aan de Tweede Kamer. Omdat dit onbekend was, staan hierover ook geen eisen in de regelgeving voor deze installaties.
Lees de hele Kamerbrief
Acute infectie
Het risico ontstaat voor zover nu bekend vooral "als de installaties waar beluchting plaatsvindt van voedingsrijk warm water niet is afgedekt". De minister laat onderzoeken welke nieuwe eisen aan biologische waterzuiveringsinstallaties moeten worden gesteld. Legionella kan een acute infectie van de luchtwegen veroorzaken.
Meer risicovolle installaties
Er zijn meer dan tweehonderd biologische waterzuiveringsinstallaties. Hier wordt bedrijfsafvalwater gezuiverd met behulp van bacteriën. Bij de betrokken overheidsdiensten zijn - behalve de twee bekende gevallen in het Brabantse Boxtel en Son - geen acute problemen bekend. Onderzocht wordt of er nog meer risicovolle installaties zijn.
Het risico ontstaat voor zover nu bekend vooral "als de installaties waar beluchting plaatsvindt van voedingsrijk warm water niet is afgedekt". De minister laat onderzoeken welke nieuwe eisen aan biologische waterzuiveringsinstallaties moeten worden gesteld. Legionella kan een acute infectie van de luchtwegen veroorzaken.
Meer risicovolle installaties
Er zijn meer dan tweehonderd biologische waterzuiveringsinstallaties. Hier wordt bedrijfsafvalwater gezuiverd met behulp van bacteriën. Bij de betrokken overheidsdiensten zijn - behalve de twee bekende gevallen in het Brabantse Boxtel en Son - geen acute problemen bekend. Onderzocht wordt of er nog meer risicovolle installaties zijn.
'Verspreiding had voorkomen kunnen worden'
Eerder bracht ZEMBLA naar buiten dat er internationaal-wetenschappelijke informatie voorhanden is die verspreiding van de legionellabacterie bij waterzuiveringsinstallaties in Son en Boxtel had kunnen voorkomen. Die informatie zagen de GGD’s Hart voor Brabant en Brabant-Zuidoost tijdens het bronnenonderzoek over het hoofd. In totaal raakten de afgelopen jaren in de omgeving van de installaties in Son en Boxtel zeker 22 mensen besmet.
Volg ZEMBLA ook op LinkedIn
Bron: ANP
Eerder bracht ZEMBLA naar buiten dat er internationaal-wetenschappelijke informatie voorhanden is die verspreiding van de legionellabacterie bij waterzuiveringsinstallaties in Son en Boxtel had kunnen voorkomen. Die informatie zagen de GGD’s Hart voor Brabant en Brabant-Zuidoost tijdens het bronnenonderzoek over het hoofd. In totaal raakten de afgelopen jaren in de omgeving van de installaties in Son en Boxtel zeker 22 mensen besmet.
Volg ZEMBLA ook op LinkedIn
Bron: ANP
Meer over:
legionellaPraat mee
Reacties (0)
Zembla nieuwsbrief
Schrijf je in voor de Zembla-nieuwsbrief en blijf op de hoogte van onze onthullende journalistiek.